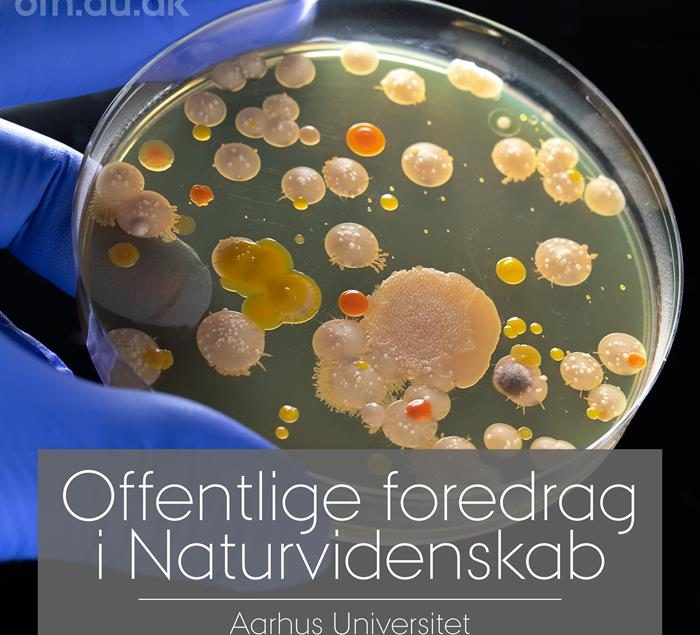

Gratis Foredrag: Vil resistente bakterier slå os ihjel?
6. maj, 2025 kl. 18:45 til 21:00 · Arrangør: Mesing Borgerforening
Kom til hyggelig gratis foredrag i Mesing Forsamlingshus. Live streaming fra AU. Kaffe og kage kan købes.
Aftensemne:
Et af de største fremskridt i lægevidenskaben er opdagelsen af antibiotika, men hvordan virker de egentlig og hvorfor rammer de ikke vores egne celler? Hør om bakterier, antibiotika og om mulige løsninger på de fremvindende resistente bakterier.